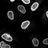

Synopsis of Social media discussions
Discussions show enthusiasm for the new ImageJ toolset, with comments like 'another useful ImageJ toolset' and appreciation for collaborative efforts, demonstrating positive tone and technical focus. Words like 'great collaboration' and 'thanks' reflect genuine interest, while anticipation of the publication indicates moderate engagement and potential impact.
Agreement
Moderate agreementMost discussions express positive recognition of the toolset, highlighting its usefulness and collaborative development.
Interest
High level of interestThe detailed mentions of the technical collaboration and anticipation of the paper's release indicate high interest.
Engagement
Moderate level of engagementParticipants reference programming, collaborations, and upcoming publications, showing moderate engagement with the content.
Impact
Moderate level of impactComments suggest the tool could positively influence research workflows but do not claim it will revolutionize the field, indicating moderate impact.
Social Mentions
YouTube
4 Videos
13 Posts
News
21 Articles
Metrics
Video Views
609
Total Likes
50
Extended Reach
28,055
Social Features
38
Timeline: Posts about article
Top Social Media Posts
Posts referencing the article

ZFBONE: Semi-Automatic Analysis of Zebrafish Bone Structures
This tutorial explains the ZFBONE macro for assessing zebrafish bone structures in wildtype and transgenic larvae using specific stains and fluorescent proteins.

ZFBONE: Automated Analysis of Zebrafish Bone Structures
The caudal fin assay assesses mineral content, ray morphometry, or osteoclast activity in regenerated fins stained with bone-specific dyes like alizarin red S or calcein. Explore the ZFBONE toolset for semi-automatic analysis of zebrafish bone structures.

Automated Analysis of Zebrafish Bone Scales Using ZFBONE Toolset
This tutorial demonstrates how to use ZFBONE, an ImageJ toolset for semi-automatic analysis of zebrafish bone scales, including osteoclast activity and mineralization assessment through TRAP and von Kossa staining.

ZFBONE Ray Bone Intensity Analysis Tutorial
The ray bone intensity assay assesses caudal fin ray intensity from microCT images. The tutorial covers both manual pixel analysis and data pooling for comparing fin data, providing insights into zebrafish bone structure analysis using ZFBONE.
-

ZFBONE: An ImageJ toolset for semi-automatic analysis of zebrafish bone structures https://t.co/onkByh7AeJ! @CienciasDoMar Poke @EMBRC_EU
view full postJuly 27, 2020
-

João Cardeira-da-Silva
@joao_cardeira (Twitter)RT @fab_cordelieres: An yet another useful ImageJ toolset ! A great collaboration with @marco_tarasco who learned and did the programming,…
view full postJune 17, 2020
11
-

BioloGeek
@Nico_BioloGeek (Twitter)RT @fab_cordelieres: An yet another useful ImageJ toolset ! A great collaboration with @marco_tarasco who learned and did the programming,…
view full postJune 12, 2020
11
-

Kota Miura
@cmci_ (Twitter)RT @fab_cordelieres: An yet another useful ImageJ toolset ! A great collaboration with @marco_tarasco who learned and did the programming,…
view full postJune 11, 2020
11
-

Robert Haase
@haesleinhuepf (Twitter)RT @fab_cordelieres: An yet another useful ImageJ toolset ! A great collaboration with @marco_tarasco who learned and did the programming,…
view full postJune 11, 2020
11
-

Julia Fernandez
@juliafrodri (Twitter)RT @fab_cordelieres: An yet another useful ImageJ toolset ! A great collaboration with @marco_tarasco who learned and did the programming,…
view full postJune 11, 2020
11
-

Imaging Core Facility
@imcf_basel (Twitter)RT @fab_cordelieres: An yet another useful ImageJ toolset ! A great collaboration with @marco_tarasco who learned and did the programming,…
view full postJune 11, 2020
11
-

Oliver Biehlmaier
@Biehli (Twitter)RT @fab_cordelieres: An yet another useful ImageJ toolset ! A great collaboration with @marco_tarasco who learned and did the programming,…
view full postJune 11, 2020
11
-

MFM_Microscopy
@RTMFM1 (Twitter)RT @fab_cordelieres: An yet another useful ImageJ toolset ! A great collaboration with @marco_tarasco who learned and did the programming,…
view full postJune 11, 2020
11
-

fabrice senger
@fabrice_senger (Twitter)RT @fab_cordelieres: An yet another useful ImageJ toolset ! A great collaboration with @marco_tarasco who learned and did the programming,…
view full postJune 11, 2020
11
-
Anna Klemm
@ahklemm (Twitter)RT @fab_cordelieres: An yet another useful ImageJ toolset ! A great collaboration with @marco_tarasco who learned and did the programming,…
view full postJune 11, 2020
11
-

jeromemutterer
@jmutterer (Twitter)RT @fab_cordelieres: An yet another useful ImageJ toolset ! A great collaboration with @marco_tarasco who learned and did the programming,…
view full postJune 11, 2020
11
-

Fabrice Cordelieres
@fab_cordelieres (Twitter)An yet another useful ImageJ toolset ! A great collaboration with @marco_tarasco who learned and did the programming, thanks to @NEUBIAS_COST STSM ! The paper is on its way out ;-) ZFBONE: An ImageJ toolset for semi-automatic analysis of zebrafish bon... https://t.co/PxkGDGeSo3
view full postJune 11, 2020
34
11
-
Leonor Cancela (8917-3248-BC8E) | CIÊNCIAVITAE
"ZFBONE: An ImageJ toolset for semi-automatic analysis of zebrafish bone structures". Bone 138 (2020): 115480. http://dx.doi.org/10.1016/j.bone.2020.115480 ...
view full postDecember 11, 2025
All
-
Leonor Cancela
"ZFBONE: An ImageJ toolset for semi-automatic analysis of zebrafish bone structures". Bone, 138. https://doi.org/10.1016/j.bone.2020.115480. Carletti ...
view full postDecember 11, 2025
All
-
Fabrice CORDELIÈRES | Research engineer | PhD | French ...
ZFBONE: An ImageJ toolset for semi-automatic analysis of zebrafish bone structures. Article. Jun 2020. Marco Tarasco ...
view full postDecember 11, 2025
All
-
Matrix first, minerals later: fine-tuned dietary phosphate increases ...
32. Tarasco. M. ,. Cordelières. FP. ,. Cancela. ML. ,. Laizé. V . ZFBONE: an ImageJ toolset for semi-automatic analysis of zebrafish bone structures . Bone .
view full postDecember 11, 2025
All
-
Rekomendasi Teknik Analisis Citra SEM Dengan Menggunakan ...
ZFBONE: An ImageJ toolset for semi-automatic analysis of zebrafish bone structures. Bone, 138: 115480. Torre, I.G., Heck, R.J., Tarquis, A.M. (2020) ...
view full postDecember 11, 2025
All
-
Zebrafish as a Model to Unveil the Pro-Osteogenic Effects ... - Frontiers
Fluorescence images were processed with ZFBONE macro toolset for Fiji (40). ... ZFBONE An ImageJ toolset for semi-automatic analysis of zebrafish bone structures.
view full postDecember 11, 2025
All
-
ZFBONE: An ImageJ toolset for semi-automatic analysis of zebrafish ...
ZFBONE: An ImageJ toolset for semi-automatic analysis of zebrafish bone structures. Author links open overlay panel. Marco Tarasco a , Fabrice P. Cordelières ...
view full postDecember 11, 2025
All
-
Zebrafish mutants reveal unexpected role of Lrp5 in ... - Frontiers
ZFBONE: An ImageJ toolset for semi-automatic analysis of zebrafish bone structures. Bone (2020) 138:115480. doi: 10.1016/j.bone.2020.115480. PubMed Abstract ...
view full postDecember 11, 2025
All
-
M.LEONOR CANCELA - Loop
ZFBONE: An ImageJ toolset for semi-automatic analysis of zebrafish bone structures. Marco Tarasco; Fabrice P. Cordelières; M. Leonor Cancela · Vincent Laizé.
view full postDecember 11, 2025
All
-
Phosphatidylglycerol determination on amniotic fluid 10,000 × g ...
ZFBONE: An ImageJ toolset for semi-automatic analysis of zebrafish bone structures. Bone, Volume 138, 2020, Article 115480. Marco Tarasco, …, Vincent Laizé ...
view full postDecember 11, 2025
All
-
Marco Tarasco - Google Scholar
ZFBONE: An ImageJ toolset for semi-automatic analysis of zebrafish bone structures. M Tarasco, FP Cordelieres, ML Cancela, V Laize. Bone 138, 115480, 2020. 30 ...
view full postDecember 11, 2025
All
-
Harnessing the immune system to treat bone loss: The ...
Tarasco, et al., ZFBONE: An ImageJ toolset for semi-automatic analysis of zebrafish bone structures. Bone 138, 115480 (2020). 85. CLC ...
view full postFebruary 19, 2025
All
-
Bone cell differentiation and mineralization in wild-type and ...
... ImageJ toolset ZFBONE. RNA extraction. RNA was ... ZFBONE: an ImageJ toolset for semi-automatic analysis of zebrafish bone structures.
view full postJanuary 17, 2025
All
-
foxe1 mutant zebrafish show indications of a hypothyroid phenotype ...
... zebrafish mutants in the present study. Thyroid ... ZFBONE: an ImageJ toolset for semi-automatic analysis of zebrafish bone structures.
view full postOctober 3, 2024
All
-
COverlap: a Fiji toolset for the 3D co-localization... | F1000Research
Bioimage analysis workflows being largely underreported in method sections of articles, it is however quite difficult to find practical examples ...
view full postJanuary 3, 2024
All
-
Recent Advances in Bioimage Analysis Methods for Detecting ...
ZFBONE: An ImageJ toolset for semi-automatic analysis of zebrafish bone structures. Bone. 2020;138:115480. doi: 10.1016/j.bone.2020.115480 ...
view full postDecember 14, 2023
All
-
Detailed Reference - ORBi
ZFBONE: An ImageJ toolset for semi-automatic analysis of zebrafish bone structures Bone 2020 138 115480 10.1016/j.bone.2020.115480 32534223 ...
view full postDecember 14, 2023
All
-
The osteogenic and mineralogenic potential of the microalgae ...
... ZFBONE macro-toolset for Fiji [34]. The area of the ... ZFBONE: An ImageJ toolset for semi-automatic analysis of zebrafish bone structures.
view full postSeptember 30, 2023
All
-
Screening of Mineralogenic and Osteogenic Compounds in ...
ZFBONE: An ImageJ toolset for semi-automatic analysis of zebrafish bone structures. Bone. 2020;138:115480. doi: 10.1016/j.bone.2020.115480 ...
view full postAugust 10, 2022
All
-
Antioxidant and Anti-inflammatory Extracts From Sea ... - Frontiers
ZFBONE: an imageJ toolset for semi-automatic analysis of zebrafish bone structures. Bone. (2020) 138:115480. doi: 10.1016/j.bone.2020.115480.
view full postMay 8, 2022
All
-
ZFBONE: An ImageJ toolset for semi-automatic analysis of zebrafish ...
ZFBONE: An ImageJ toolset for semi-automatic analysis of zebrafish bone structures. Bone. 2020 Sep:138:115480. doi: 10.1016/j.bone ...
view full postJune 11, 2020
All
Abstract Synopsis

France-BioImaging Research Infrastructure
@Fr_BioImaging (Twitter)